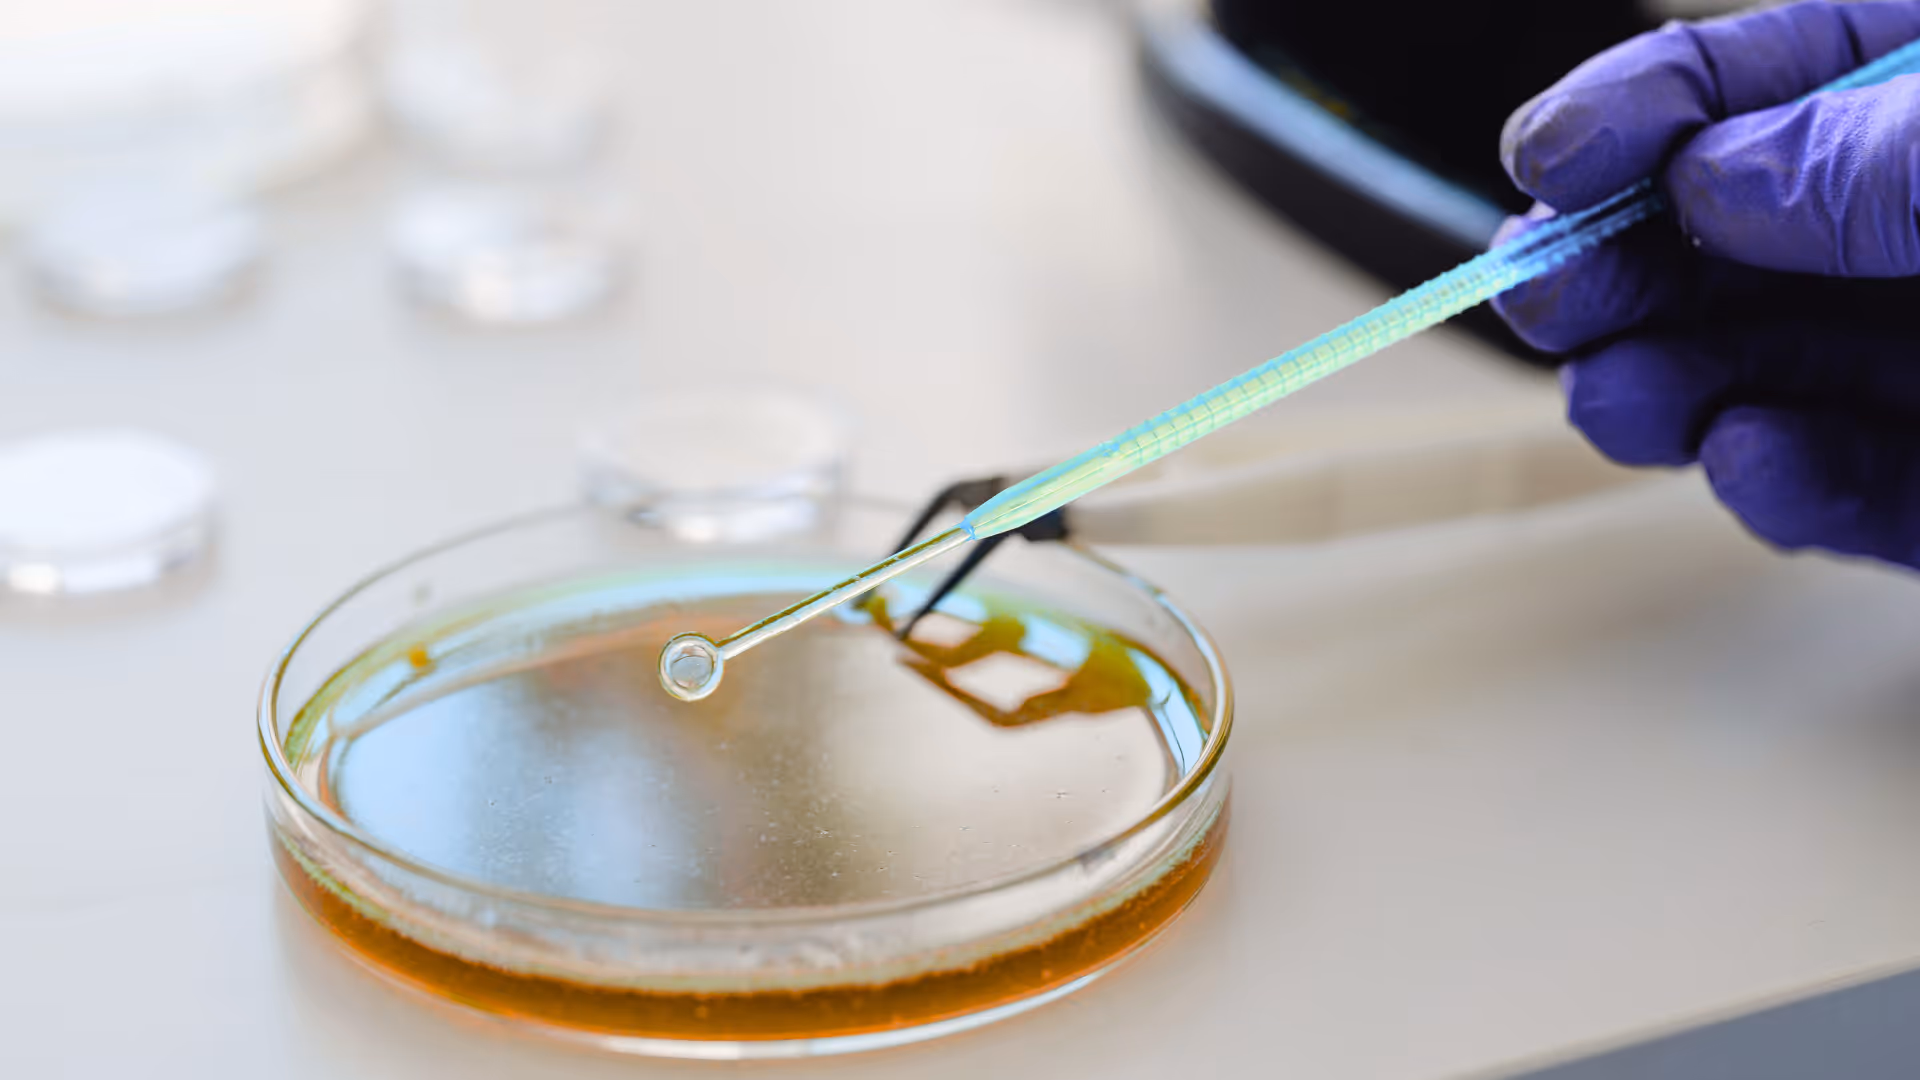
Une main gantée manipule une anse métallique sur une boîte de Pétri contenant un milieu de culture.

PlusOne, le partenaire en recrutement stratégique des start-ups, PME et entreprises en Belgique et à l’international.
entreprises accompagnées
de taux de rétention, 12 mois après la prise de fonction
profils qualifiés dans notre base de données un réseau activé au quotidien
experts, managers et dirigeants recrutés

Executive Search
Notre cœur de métier.
Nous accompagnons les entreprises dans leurs recrutements en identifiant les meilleurs profils et en sécurisant les prises de décision.
Jobs Posted
Trusted Companies
C-Level & dirigeants commerciaux
Recruter un dirigeant demande une expertise spécifique, une capacité à comprendre les dynamiques de l’entreprise et les enjeux qui en découlent.
Jobs Posted
Trusted Companies

Découvrez nos dernières offres

Chief Financial Officer - PME industrielle

Customer Quality Partner - CDMO
Restez informés des dernières tendances du recrutement
Observer et décrypter les mutations du recrutement et de l'IA
FAQs
PlusOne se différencie d'une part par sa spécialisation dans les secteurs de la biotech, medtech, hightech et greentech ainsi que par l’accompagnement pointu et personnalisé que nous proposons à nos clients. Nous ne nous contentons pas de pourvoir un poste. Nous analysons le contexte, les enjeux stratégiques et la culture d’entreprise afin d’identifier des profils alignés à la fois sur les compétences, les valeurs et la vision de l’organisation. Notre approche se veut personnalisée, exigeante et orientée long-terme.
PlusOne accompagne principalement des entreprises actives dans les secteurs Biotech, Medtech, Hightech et Greentech. Ces environnements complexes et innovants nécessitent une compréhension fine des enjeux techniques, scientifiques et humains, que nous maîtrisons depuis quinze ans.
Chez PlusOne, nous recrutons des experts, des managers, des profils C-Level (CEO, CTO, CFO, CSO…), ainsi que des talents stratégiques capables d’accompagner la croissance et la transformation des organisations. Chaque mission est abordée comme une décision stratégique pour l’avenir de l’entreprise. Plus généralement depuis 2011 nous couvrons le recrutement de profils de scientifiques et ingénieurs de tout type.
Chez PlusOne, nous combinons une approche approfondie du contexte, une méthodologie rigoureuse, un réseau qualifié de plus de 25 000 profils construit sur le long terme et des outils d’évaluation reconnus comme Lumina, par exemple. Notre objectif est de réduire les risques liés au recrutement et de garantir un alignement durable entre l’entreprise et le candidat. Notre taux de rétention, 12 mois après la prise de fonction est de 85%, ce qui montre que notre approche est pertinente et efficace.
Depuis 15 ans, PlusOne a accompagné plus de 150 entreprises de toutes tailles : aussi bien des start-ups et scale-ups ambitieuses que des PME établies et des filiales de groupes internationaux. Ce qui compte avant tout, ce sont les enjeux stratégiques du recrutement et la volonté de construire une collaboration solide et durable.
Chez PlusOne, chaque mandat est abordé comme une décision stratégique pour l’entreprise cliente. Nous commençons par analyser en profondeur le contexte, les enjeux, la culture d’entreprise et les objectifs à court, moyen et long terme. Cette phase de diagnostic nous permet de clarifier le besoin réel, parfois au-delà de l’intitulé du poste, afin d’identifier des talents qui auront un impact durable.

.avif)